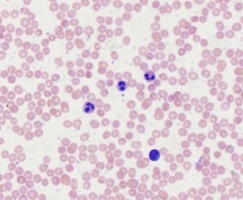

This content is based on two digital products, Digital Slides for Medical Histology (DSMH) and Digital Slides for Animal Histology (DSAH). It is stated in the following 20 chapters.
Click one of the following photos to enter the respective chapter.
Digestive System (I)
Digestive System (II)
Digestive System (III)
Respiratory System
Urinary System
Male Genital System
Female Genital System
Endocrine System
Central Nervous System
Special Sense Organs
NOTE: This webpage is still under construction and will be available by the end of 2025.